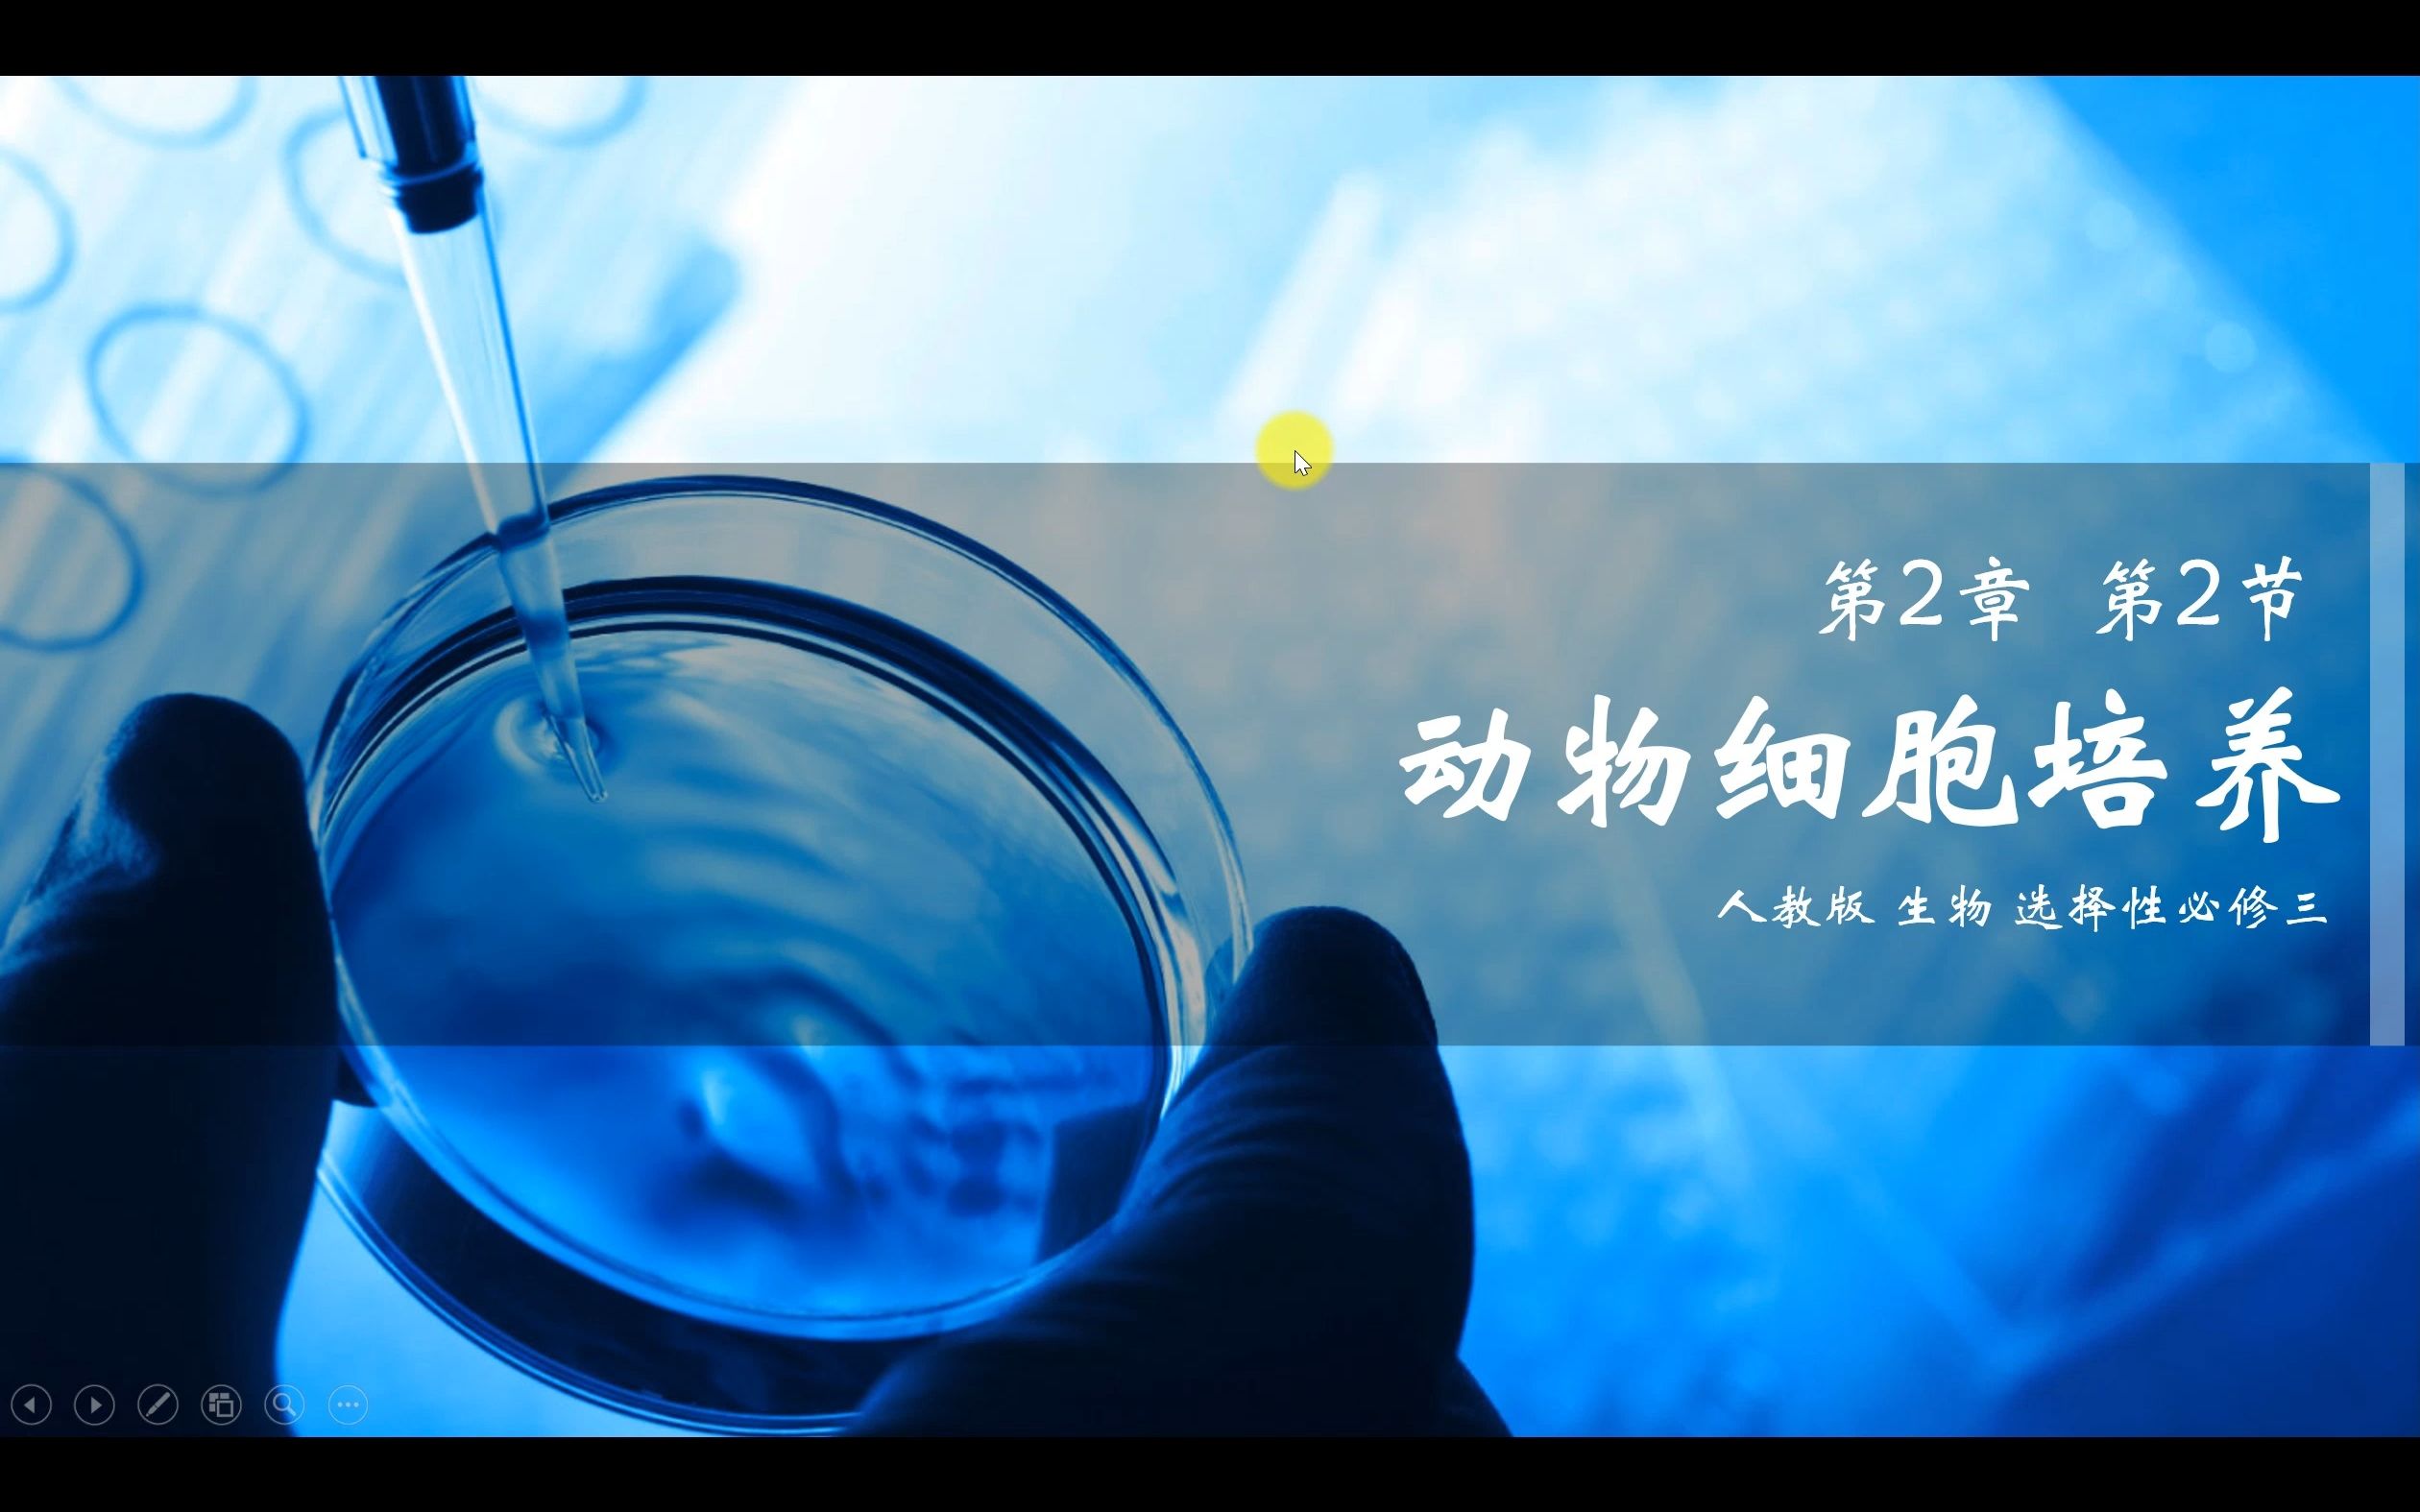
2.1 动物细胞培养
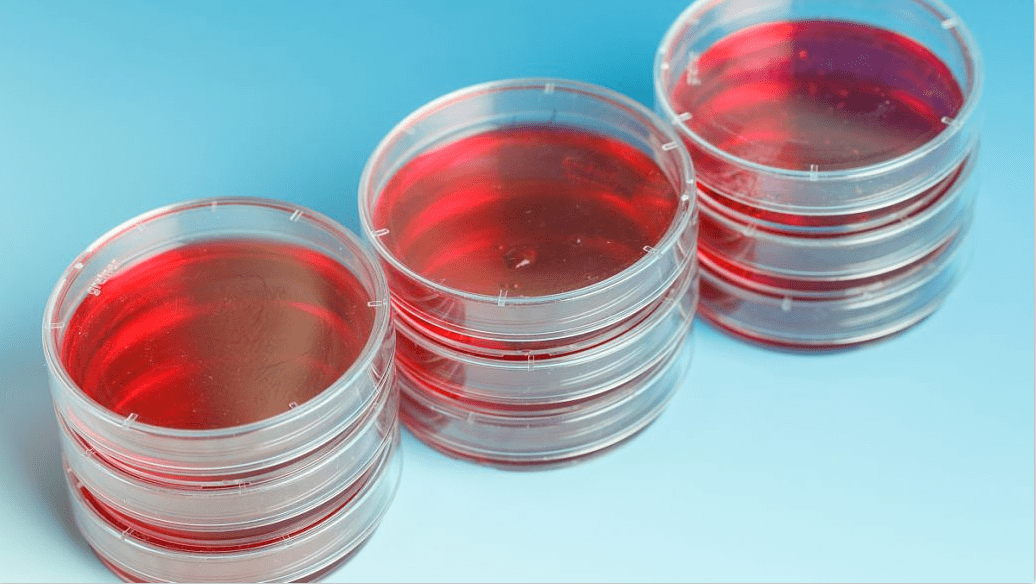
含有丰富的细胞生长必须的营养成份,常用于动物细胞的体外培养,具有极

动物细胞培养

2动物细胞工程(动物细胞培养) 课件 2课时打包
图片尺寸860x484
2.1 动物细胞培养
图片尺寸2520x1575
生物人教版2019选择性必修3221动物细胞培养课件共34张ppt
图片尺寸860x484
动物细胞组织培养ppt
图片尺寸1080x810![动物细胞培养和核移植技术(上课用)[1]ppt](https://i.ecywang.com/upload/1/img1.baidu.com/it/u=639592045,495695024&fm=253&fmt=auto&app=138&f=JPEG?w=500&h=375)
动物细胞培养和核移植技术(上课用)[1]ppt
图片尺寸1080x810
【二手9成新】动物细胞培养:基本技术指南(第5版) /r.i.弗雷谢尼 科学
图片尺寸1600x2133![【二手9成新】动物细胞培养:基本技术指南(第5版) /[英]r.i.](https://i.ecywang.com/upload/0/t13.baidu.com/it/u=959799285,1887207340&fm=224&app=112&f=JPEG?w=375&h=500)
【二手9成新】动物细胞培养:基本技术指南(第5版) /[英]r.i.
图片尺寸900x1200
动物细胞培养--基本技术和特殊应用指南(原书第7版)/生命科学实验指南
图片尺寸1000x1000
【二手9成新】动物细胞培养——基本技术和特殊应用指南(原书第六版)
图片尺寸1600x2134
【二手9成新】动物细胞培养——基本技术和特殊应用指南(原书第六版)
图片尺寸1600x2133
动物细胞培养
图片尺寸1920x2560
【二手9成新】动物细胞培养:基本技术指南(第5版) /r.i.弗雷谢尼 科学
图片尺寸1200x1200
【二手9成新】动物细胞培养——基本技术和特殊应用指南(原书第六版)
图片尺寸1600x1600
culturede meat 是利用组织工程技术在实验室环境下培养动物肌肉细胞
图片尺寸926x928
动物细胞培养和核移植技术ppt
图片尺寸920x690
动物细胞工程图解
图片尺寸1080x810
【二手9成新】动物细胞培养技术与应用 /王捷 化学工业
图片尺寸1600x2134
含有丰富的细胞生长必须的营养成份,常用于动物细胞的体外培养,具有极
图片尺寸1036x584![[二手9成新] 动物细胞培养——基本技术和特殊应用指南(原书第六](https://i.ecywang.com/upload/0/t15.baidu.com/it/u=1546477916,3305779079&fm=224&app=112&f=JPEG?w=500&h=500)
[二手9成新] 动物细胞培养——基本技术和特殊应用指南(原书第六
图片尺寸1200x1200
【二手9成新】cu|ture of animal cells 动物细胞培养
图片尺寸800x1066




![动物细胞培养和核移植技术(上课用)[1]ppt](https://i.ecywang.com/upload/1/img1.baidu.com/it/u=639592045,495695024&fm=253&fmt=auto&app=138&f=JPEG?w=500&h=375)

![【二手9成新】动物细胞培养:基本技术指南(第5版) /[英]r.i.](https://i.ecywang.com/upload/0/t13.baidu.com/it/u=959799285,1887207340&fm=224&app=112&f=JPEG?w=375&h=500)










![[二手9成新] 动物细胞培养——基本技术和特殊应用指南(原书第六](https://i.ecywang.com/upload/0/t15.baidu.com/it/u=1546477916,3305779079&fm=224&app=112&f=JPEG?w=500&h=500)

![动物细胞培养和核移植技术(上课用)[1]ppt](https://www.51wendang.com/pic/cd0397dc19cf947bc76297e8/6-810-jpg_6-1080-0-0-1080.jpg)

![【二手9成新】动物细胞培养:基本技术指南(第5版) /[英]r.i.](https://img14.360buyimg.com/pop/jfs/t1/3682/14/22030/192651/66b11b84Fdce7e438/7165876d5250d592.jpg)

![[二手9成新] 动物细胞培养——基本技术和特殊应用指南(原书第六](https://img14.360buyimg.com/pop/jfs/t1/247215/8/12481/150047/667dff05Fee3d4ee0/d10bacf4cb9f391c.jpg)
